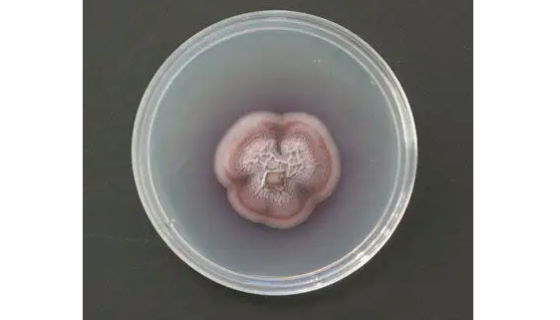
柴油食烷菌——抗药性较强（防腐试验菌）
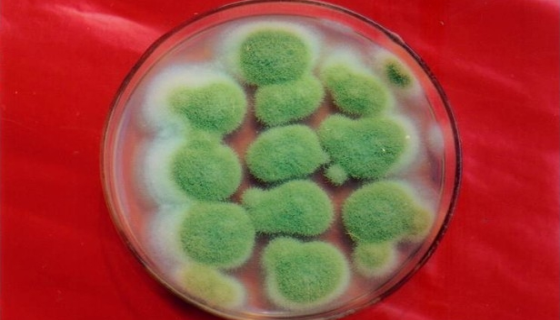
米曲霉在水产养殖中的作用机理与应用好处！

JF305人胰腺癌细胞的复苏与传代及冻存流程!
JF305人胰腺癌细胞来源于人胰腺,呈上皮细胞样,贴壁生长。

链格孢菌属的生物学特性与发生规律及主要用途!
链格孢属是一种在自然界广泛分布的暗色真菌,是土壤、植物、食品...
柴油食烷菌——抗药性较强(防腐试验菌)
柴油食烷菌是Alcanivorax属的微生物,原产地为中国。...
![U-2OS]人骨肉瘤细胞的培养操作步骤及应用!](https://biobw.oss-cn-beijing.aliyuncs.com/data/article/1678754428154372819.png)
U-2OS]人骨肉瘤细胞的培养操作步骤及应用!
U-2OS]人骨肉瘤细胞源自一名15岁女孩的胫骨中等分化的肉...

梭形芽孢杆菌——用于食品安全的研究
梭形芽孢杆菌是Bacillus属的微生物,原产地为中国。主要...

人造血干细胞的运输和保存及注意事项有哪些?
造血干细胞是骨髓中的干细胞,具有自我更新能力并能分化为各种血...
米曲霉在水产养殖中的作用机理与应用好处!
米曲霉属半知菌亚门,丝孢纲,丝孢目,梗孢科,曲霉属真菌中的一...

桦褐孔菌的功能特性与药用价值及功效作用!
桦褐孔菌是一种药用真菌, 富含 β-D-glucan (β-...

PLC/PRF/5(人肝癌亚力山大细胞)的培养与应用!
PLC/PRF/5(人肝癌亚力山大细胞)于1976年建系,细...